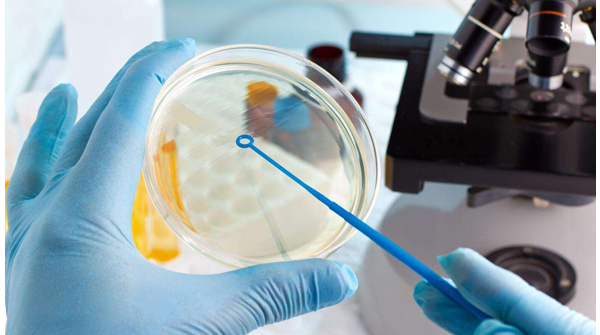
回顾试管婴儿历史，从1978年世界第一例到1988中国第一例...

-

怀孕清宫图的来源有历史依据吗?
清宫表全名清宫生男生女表,是由中国古人发明的,埋在一个有700多年历史的皇陵下。在古代清宫表具有预测生育以及生男生女的历史意义,是专供皇室进行使用的,在民国之后才..
2022-12-31 12:00 -

道教由来离不开我国历史的更替发展 由此催化出这个产物
目前我国官方认可的宗教主要有三个,那么在这三个宗教当中道教是对中国人思想影响比较深远的一个宗教,它也是这三个宗教当中一个土生土长的宗教。道教由来离不开我国历史的..
2023-04-07 23:13 -

带你回顾种生基的历史,种生基不是现代才有的
许多朋友对种生基不了解,于是觉得种生基是现代的产物。其实不然,种生基的历史其实已经相当久远,只不过在近几年来才逐渐被媒体报道和大家所熟悉。什么是生基,简单来说就..
2023-04-21 14:27 -

种生基的历史由及怎么选择生基寿坟
如何选择生基寿坟是很多人关注的问题,也是种生基中重要的环节,好的生基墓地,才能达到最好的效果。那么怎么选择生基寿坟。第一,确实地有气,现在的公墓都是排成一列,排..
2023-05-01 00:19 -
为什么艾条能辟邪?有哪些历史寓意?
艾条是一种古老的中草药,用于驱邪和祛病已有数千年的历史。在中国传统文化中,艾条被广泛应用于辟邪、保平安和祈福的仪式和功效中。本文将探讨为什么艾条能辟邪,并回顾其..
2023-12-21 14:47 -

道教历史及起源
道教是中国本土的一种宗教,起源于公元前2世纪,至今已有超过1700年的历史。它融合了多种文化元素,包括鬼神崇拜、方仙信仰和黄老道家等,形成了一个独特的宗教体系..
2024-04-24 21:13 -

探究八字的由来及历史演变
八字,是一种古老的命理算命方法,源自中国的道家文化八字中的“八”代表四柱八字,其中每个柱子都由一个天干和一个地支组成,表明一个人生命的八个方面这种算命方法在中国有着..
2024-06-25 23:48 -

八字秘诀是哪个时候提出的?历史揭秘
八字秘诀是哪个会议提出的?你可能听说过八字秘诀,这是一种中华传统的民间算命方法,据说可以根据出生时辰,年月日八个字以及农历推算一个人的命运这个秘密要诀的来源一直是..
2024-09-20 03:25 -

做试管婴儿前需要去医院登记孕产历史吗?
我之前怀孕过3次,但是因为还没有做好当父母的准备,所以就做了流产手术,后面就一直怀不上了,每次都因为不良原因胎停育了,我对此非常的难过。现在我一直在积极的调理身..
2024-12-09 09:21 -
回顾试管婴儿历史,从1978年世界第一例到1988中国第一例...
1973年,墨尔本莫纳什大学的医生报告了世界上首例试管婴儿诞生,这一成就是在多年的探索性研究之后取得的,使用人类和动物的胚胎,通过这些技术使人类配子(即卵子和精子)在..
2025-06-19 09:17 -
关于生命根基改运的历史记载,这种秘法你是否有了解过
种生基,它是生命的根基。它的意思就是将活人当死人办,利用天地灵气,将你身上的衣物、指甲、皮肤、牙齿与生辰八字一同放入洞穴当中,以求得转化命运的目的。那么今天我们..
2025-10-17 23:16
微信分享
扫描二维码分享到微信或朋友圈